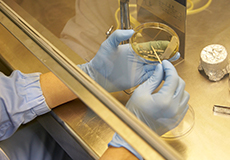

食の安全と安心
生産工場での取り組み
-
フードディフェンス体制
工場敷地への入構規定の取り決め、及び工場内に「安全安心カメラ」等を設置しています
-
異物混入防止対策
異物混入や汚染がないように工場入場に際してルールを規定し、遵守しています
-
製造工程管理
安全安心な製品作りのため、生産設備の管理、製品検査等を実施しています
外部認証取得状況
食品への異物混入、表示偽装等が相次いだ中で、食の安全・安心を求める声が高まっております。
当社としましても、「食の安全・安心」を担保するためのシステム導入へ向けての取り組みを行っております。
具体的には、食品安全マネジメントシステムFSSC22000を国内7拠点、海外1拠点で取得済みです。